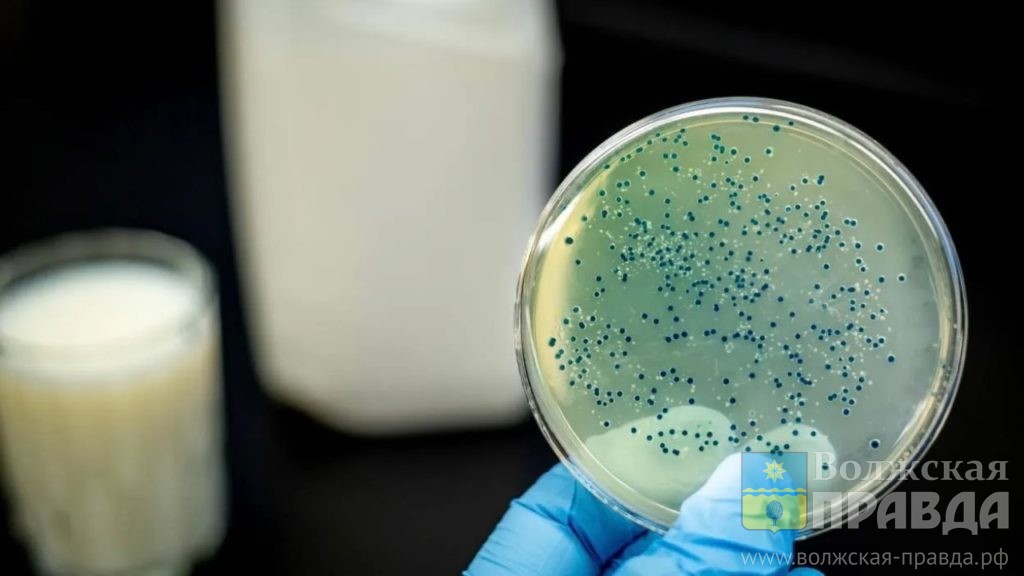

Новый очаг бруцеллеза обнаружили в Волгоградской области. В карантинную зону попало село Заплавное Ленинского района.
Опасную инфекцию подтвердили ветеринары в одном из личных подсобных хозяйств на территории поселка. В радиусе 3 километров от эпизоотического очага объявлена неблагополучная зона.
Как сообщили «Волжской правде» в региональном комитете ветеринарии, в связи с бруцеллезом в Заплавном введены запреты на оборот кормов, ввоз и вывоз животных. Поголовье больных коров будет ликвидировано.
Кстати, еще один очаг бруцеллеза на днях был обнаружен также в Ленинском районе – на животноводческой ферме в Бахтияровке. На территории сельского поселения действует ветеринарный карантин.
«Волжская правда» уже рассказывала о том, что бруцеллез опасен для человека. Им можно заразиться, употребляя мясные и молочные продукты без предварительной термической обработки. В зоне риска – приобретение продуктов на стихийных рынках и у частников. За август и сентябрь в Волгоградской области было зарегистрировано 12 случаев опасной инфекции. Причем, 8 заболевших оказались жителями Волжского, среди которых четверо детей
Читайте «Волжскую правду», где вам удобно: Новости, Одноклассники, ВКонтакте, Telegram, Дзен. Есть тема для новости? Присылайте информацию на почту vlzpravda@mail.ru


















